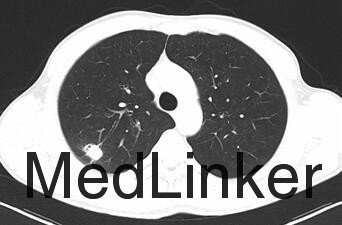

下载或打开 医联APP 查看完整评论
立即下载
打开APP
患者,男,46岁,体检发现肺部阴影2+月,咳嗽1+月”入院。患者2+月前体检发现肺部异常阴影。1+月前,患者无明显诱因出现咳嗽,起初伴有咳少量白色泡沫状痰,自行服止咳药(具体药物及剂量不详)后症状无明显好转。
CT增强:右肺上叶软组织影,伴胸膜牵拉,多系周围型肺癌。全身骨扫描:全身骨显像未见异常征象。腹部彩超:胆囊壁固醇沉积 脾脏长大。肺功能测定:肺功能正常。
诊断:肺部占位:周围性肺癌?在全麻下行VATS右肺上叶楔形切除活检+右肺上叶切除+淋巴结清扫+胸膜粘连烙断术。术中见:结节均位于右肺上叶后段,约2.2cm*1.4cm大小,脏层胸膜皱缩。术后诊断:右肺上叶腺癌
胸膜牵拉指肿瘤与胸膜之间的线形或幕状阴影,也可为星状阴影,系肿瘤瘤体内的瘢痕组织牵拉临近的脏层胸膜所致。以腺癌和细支气管肺泡癌多见。有时良性病变如结核球等也可以出现此征。